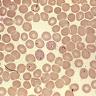

List of Tick Borne Diseases
Did you just find a tick on yourself or a loved one? TickCheck can test your tick and determine whether it carries the bacteria that transmit Lyme disease and other tick-borne infections.

Ticks can carry a wide range of diseases.
As one of the most dangerous disease vectors in North America, there are over a dozen tick-borne diseases of various severity which can be transmitted to both humans and animals through a tick bite. It can take weeks for human testing to detect these vectors.
At TickCheck, we can determine if your tick carries any of the disease-causing agents below. The most common tick-borne disease in the wild, and our most commonly requested test, is for Lyme disease. To order a tick test, visit the tick test order form.
-

Lyme disease (Borrelia burgdorferi)
Lyme disease, caused by the bacteria Borrelia burgdorferi, is the most common tick-borne disease in the northern hemisphere. Lyme disease is transferred by the bite of an infected tick, and is dangerous to both people and pets. Infection can cause severe long-term health issues including fever, fatigue, migraines, and skin rash. Left untreated, Lyme disease can spread to the joints, heart, and nervous system. With prompt diagnosis, Lyme disease can be successfully treated with several weeks of strong antibiotics.
-

anaplasmosis (Anaplasma phagocytophilum)
Anaplasmosis (formerly HGE Ehrlichia, or Human Granulocytic Ehrlichiosis) is a tick-borne disease caused by the bacterium Anaplasma phagocytophilum. Left untreated, anaplasmosis can result in bleeding or kidney failure. Anaplasma infections are also common in dogs. This disease has immediate symptoms similar to Lyme disease, and is thus difficult to diagnose and treat without lab analysis of the tick vector. Our lab uses PCR to determine the existence of the bacterium in a tick specimen.
-

babesiosis (Babesia microti)
Babesia is a tick-borne protozoan parasite that causes symptoms similar to malaria, and can pose severe health issues or even death in individuals with weak immune systems. Babesia can also cause problems in dogs. Babesia is curable in humans and animals with several modern antibiotic treatments. Our lab can determine if your tick specimen was infected with Babesia protozoa.
-

ehrlichiosis (Ehrlichia chaffeensis)
human monocytic ehrlichiosisHME Ehrlichia, or Human Monocytotropic Ehrlichiosis, is a tick-borne disease caused by the bacterium Ehrlichia chaffeensis. The bacterium infects the immune system, and can cause serious health issues including bleeding disorders. Other symptoms include fever, headache, and myalgia. When discovered, Ehrlichiosis is treatable with the antibiotic Doxycycline. Our lab can determine if your specimen is a carrier of Ehrlichia species, however our test is not specific to E. chaffeensis.
-

Rocky Mountain spotted fever (Rickettsia spp.)
Rocky Mountain Spotted Fever is the most lethal and most frequently reported rickettsial illness in the United States. Caused by the bacterium Rickettsia rickettsii and spread by Dog ticks and Lone Star ticks, the disease results in fever, abdominal pain, and a spotted rash on the skin. If not treated promptly, Rocky Mountain spotted fever can be fatal. However, prompt modern antibiotic therapy has dramatically reduced the number of deaths caused by the disease. Our lab can determine if your specimen is a carrier of Rickettsia species, but is not specific to Rickettsia rickettsii.
-

tularemia (Francisella tularensis)
Tularemia, also known as Pahvant Valley plague or Rabbit Fever, is a tick-borne disease caused by the bacterium Francisella tularensis. Used as a biological weapon in the past, Tularemia is extremely infectious and can result in fever, lethargy, anorexia, septicemia (blood infection), and even death. If diagnosed, Tularemia is treatable with powerful antibiotics like streptomycin or doxycycline.
-

B. miyamotoi (Borrelia miyamotoi)
Borrelia miyamotoi is a spiral-shaped bacterium that can transferred to humans through the deer tick. It is related to the bacterium that causes Lyme disease. Although infection can cause some similar symptoms including fever, headache, fatigue, and muscle aches, acute Lyme disease often presents with rash while infection with B. miyamotoi does not. Physicians have successfully treated patients infected with B. miyamotoi with a 2-week course of doxycycline.
-

STARI (Borrelia lonestari)
southern tick-associated rash illnessBorrelia lonestari is suspected of causing STARI, however, further research is does not support this idea. Currently, no diagnostic test is available for STARI, and no official treatment protocol exists, though antibiotics are generally prescribed.
-
babesiosis (Babesia spp.)
Babesia is a tick-borne protozoan parasite that causes symptoms similar to malaria, and can pose severe health issues or even death in individuals with weak immune systems. Babesia can also cause problems in dogs. Babesia has become more common in recent years, and is found in ticks even more frequently then Lyme disease. Babesia is curable in humans and animals with several modern antibiotic treatments. Our lab can determine if your tick specimen was infected with Babesia protozoa.
-

Deer tick virus (Powassan virus Lineage II)
Powassan virus Lineage IIPowassan virus also known as Deer Tick Virus is transmitted by an infected Blacklegged tick or Groundhog tick. Over the last decade cases have increased in the Northeast and Great Lakes region. Powassan is a potentially fatal disease that can cause fever, vomiting, dizziness, confusion, seizures, coma and encephalitis. Individuals with Powassan may suffer long-term neurological problems. There are no specific treatments for severe Powassan virus illness besides hospital care.
-

Lyme disease (Borrelia mayonii)
Borrelia mayonii was recently discovered in 2013 in the Wisconsin and is a spirochete bacterium which causes Lyme disease in the United States. It has currently only been found in upper Midwest States. Similar to B. burgdorferi it can cause rash, fever, headache, arthritis but also causes symptoms of nausea, vomiting, diffuse rashes and a higher concentration of bacteria in the blood. B. mayonii can be treated with several weeks of strong antibiotics.
-

ehrlichiosis (Ehrlichia ewingii)
human monocytic ehrlichiosisEhrlichiosis can be a serious infection if not treated in timely manner and is caused by the bacterium Ehrlichia ewingii. Ehrlichiosis can infect the immune system of humans and dogs and cause similar symptoms as E. chaffeensis; fever, headache, muscle pain, confusion and vomiting/diarrhea. Unlike E. chaffeensis, E. ewingii does not commonly have a rash and usually infects granulocytes. Ehrlichiosis is treatable with doxycycline.
-
Rocky Mountain spotted fever (Rickettsia amblyommii)
Rickettsia amblyommii is part of the spotted fever group of Rickettsia. It is an obligate intracellular bacteria that has been found to cause symptoms similar to Rocky Mountain spotted fever (RMSF). R. amblyomii is currently still being researched to fully understand it pathogenicity to humans.
